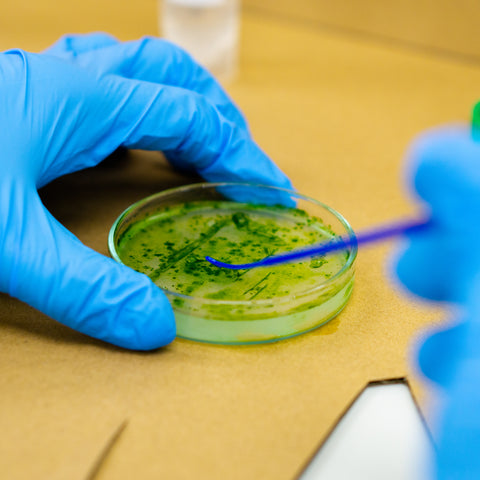

Science & Sustainability Education
Interactive STEM workshops, educational kits, and hands-on experiences for children ages 5-17. Join 1000+ young scientists learning through our programs in schools, corporate events, and community initiatives.
Hands-On STEM & Biology Workshops | Sustainability Education for Kids
As pioneers in biotech R&D, we want to bridge the gap in interactive science education. Our sustainability workshops combine biology, science, and STEAM education aligned with the UN Sustainable Development Goals. Through hands-on learning experiences, we've inspired over 1000 children to become environmental leaders.